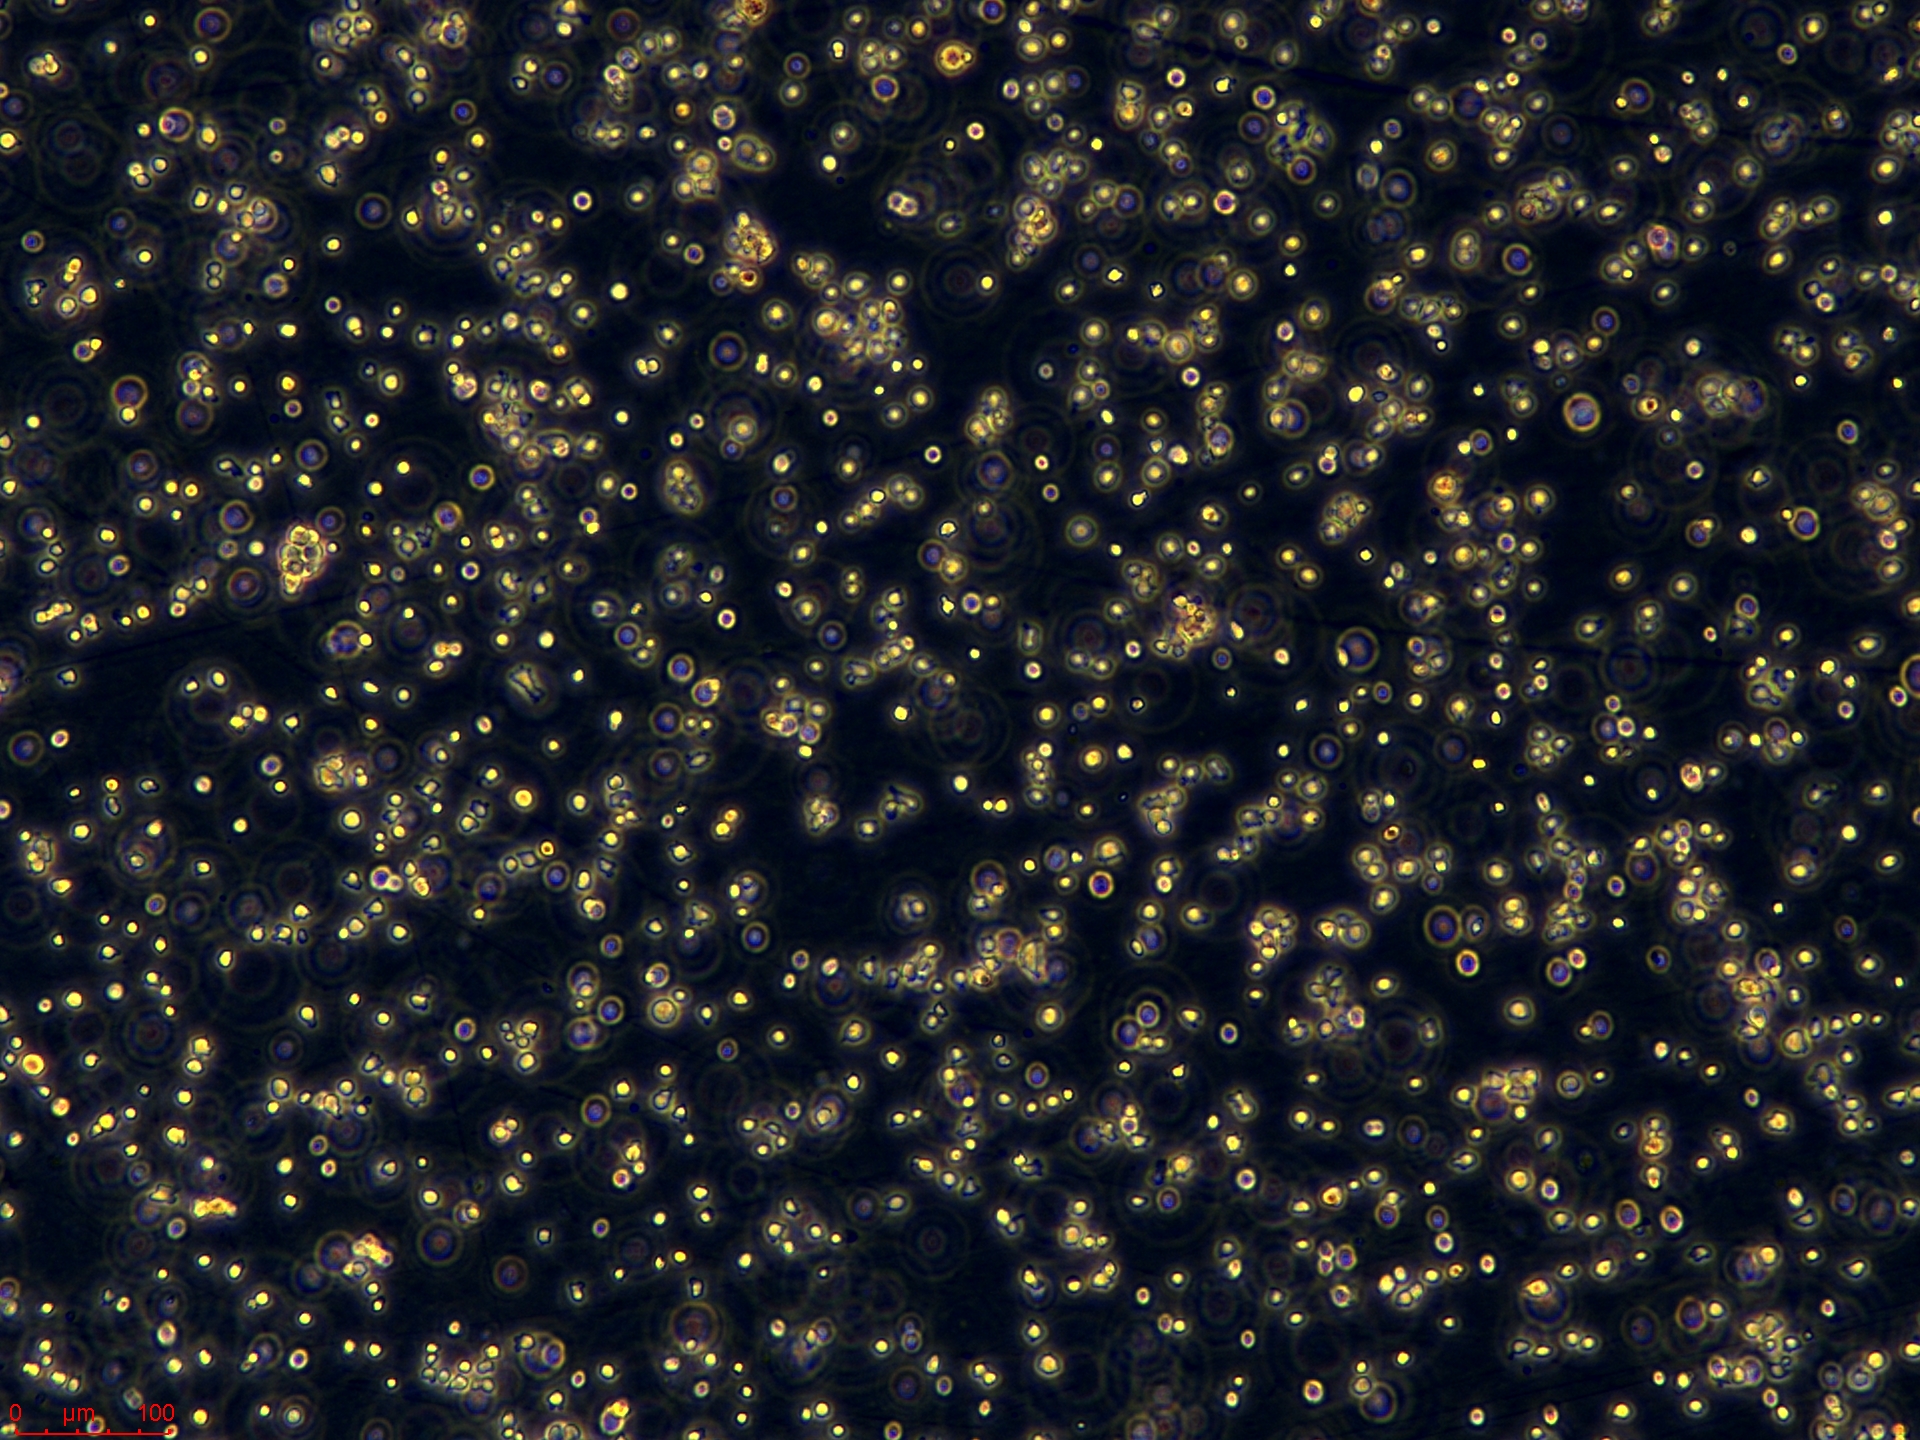
A20  高.jpg
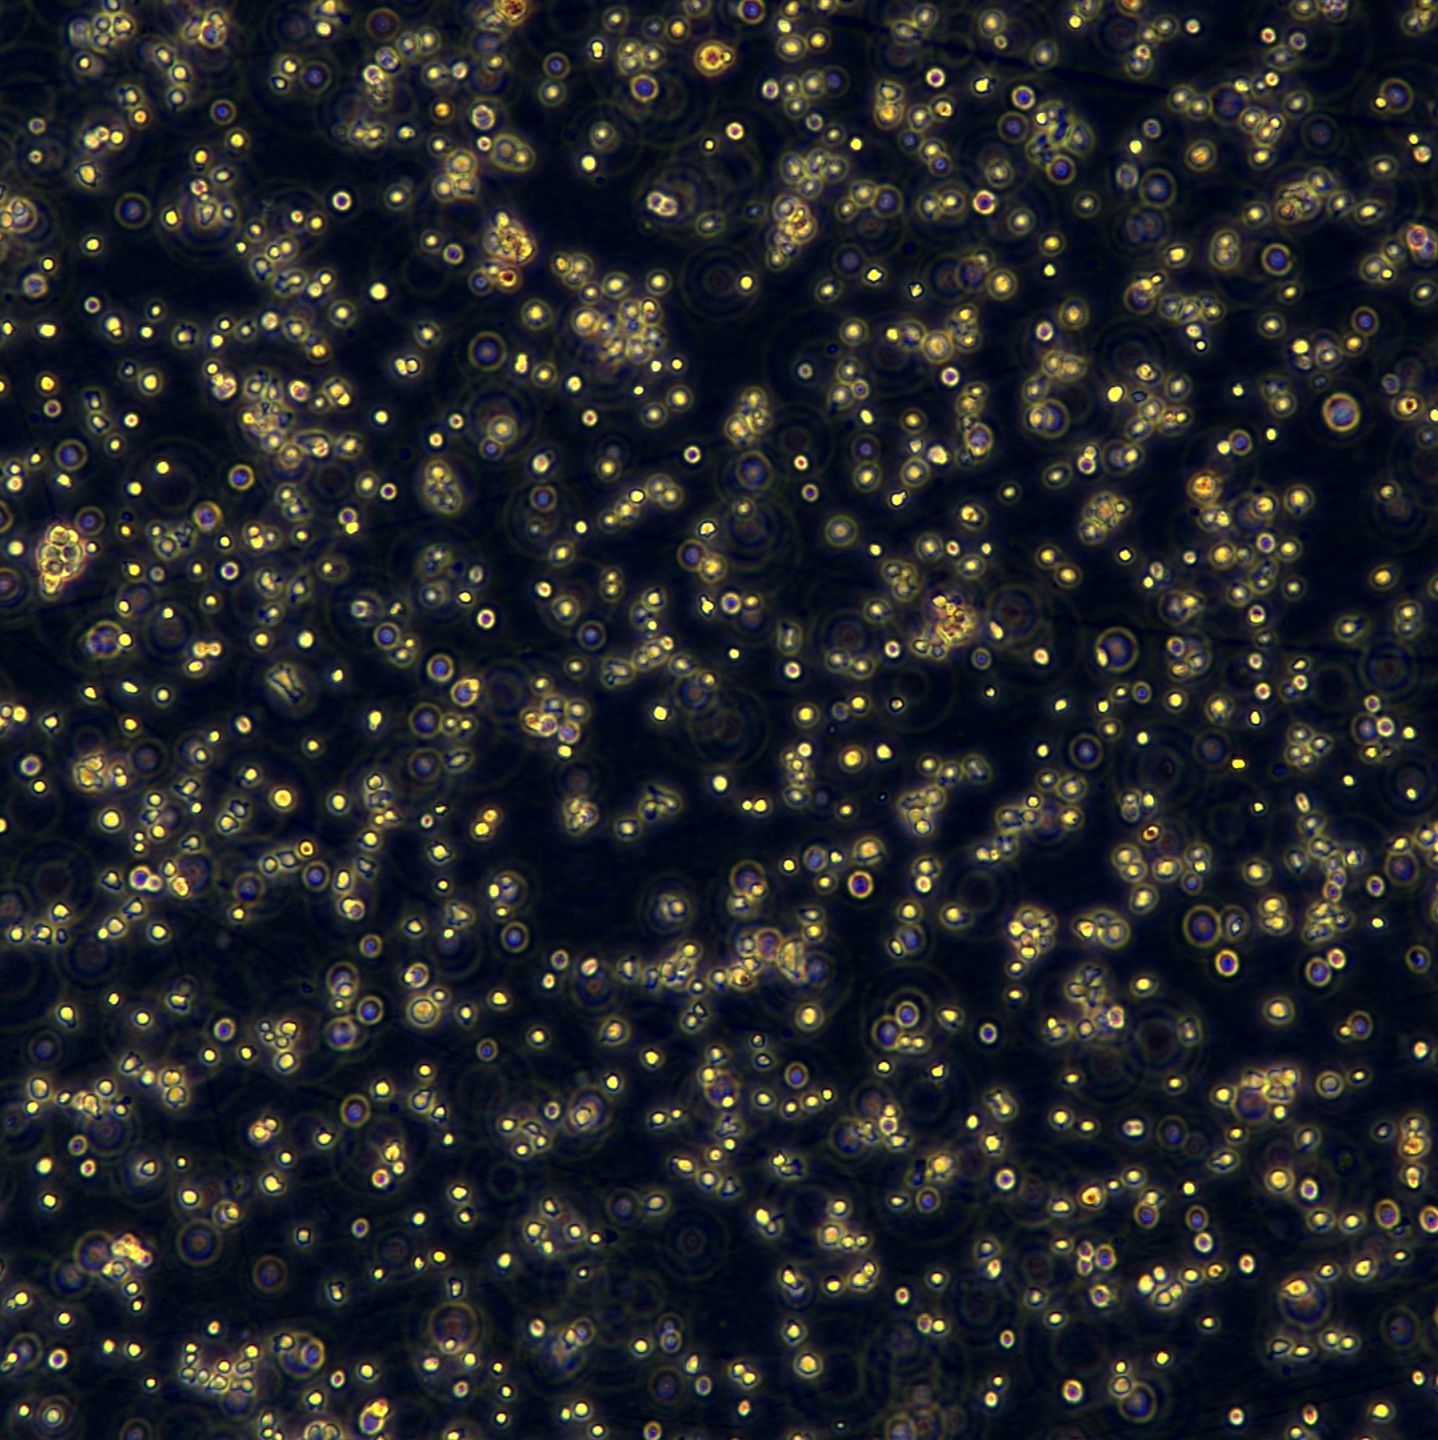
产品封面图

相关产品推荐更多 >
万千商家帮你免费找货
0 人在求购买到急需产品
- 详细信息
- 询价记录
- 文献和实验
- 技术资料
- 英文名:
A20
- 库存:
100
- 相关疾病:
网状细胞肉瘤(Reticulum cell sarcoma)
- 物种来源:
小鼠(Mus musculus)
- 细胞形态:
淋巴母细胞(Lymphoblast)
- 运输方式:
顺丰包邮
- 生长状态:
悬浮生长(Suspension)
- 规格:
T25/冻存管
| 细胞名称 | 小鼠B细胞淋巴瘤 |
| 英文名称 | A20 |
| 规格 | T25/冻存管 |
| 货号 | CTCC-007-0516 |
| 种属 | 小鼠(Mus musculus) |
| 组织来源 | 未知(Unknown) |
| 疾病 | 网状细胞肉瘤(Reticulum cell sarcoma) |
| 年龄 | 未知 |
| 培养体系 | 该细胞系培养所用基本培养基为RPMI1640 Medium,配置完全培养基时 需加入10%FBS,1% Anti-Anti。 |
| 细胞形态 | 淋巴母细胞(Lymphoblast) |
| 生长特性 | 悬浮生长(Suspension) |
风险提示:丁香通仅作为第三方平台,为商家信息发布提供平台空间。用户咨询产品时请注意保护个人信息及财产安全,合理判断,谨慎选购商品,商家和用户对交易行为负责。对于医疗器械类产品,请先查证核实企业经营资质和医疗器械产品注册证情况。
- 作者
- 内容
- 询问日期
文献和实验一、饲养环境 小鼠对环境的适应性的自体调节能力和疾病抗御能力较其他实验动物差,而小鼠的品种和品系繁多,各个品种和品系都有自己的特殊要求,因此必须根据实际情况给予一个清洁舒适的生活环境。不同等级的小鼠应生活在相应的设施中。 小鼠临界温度为低温 10℃,高温 37℃,温度中性范围 30~33℃。饲养环境控制应达到如下要求:温度 18~29℃;相对湿度 40~70%;最好控制在 18~22℃,湿度 50~60%。一般小鼠饲养盒内温度比环境高 1~2℃,湿度高 5~10%。 要保持温度、湿度相对稳定
原创 SOOF 生物学霸 2022-04-20 17:59 4 月 12 日,江苏集萃药康生物科技股份有限公司开启申购,在公司公开的招股书中显示该公司主营业务为实验动物小鼠模型的研发、生产、销售及提供相关技术服务。部分品系的小白鼠单价高达万元以上,部分品系毛利率更是高达95% 左右。 随后一条「如何看待南大教授靠卖基因敲除小鼠,一只11723元,年赚近4亿」的讨论登上知乎热榜。 图片来源:知乎 作为天坑专业之首的生物,一直以来在大家的印象里总是和辛苦,清贫,回报周期长的标签挂钩
作为实验动物中的最为炙手可热的一员,小鼠在人们认识生命现象了解相应机理过程中发挥了无可替代的作用,在基础医学研究领域内更是拥有无与伦比的地位。那么,这群拉丁名为 Musmusculus 的小动物是如何从最初的 home mouse 演变为 laboratory mouse,成为实验动物界的制霸呢? 故事需要追溯到 100 多年前。1900 年,尘封 30 多年的 Mendel 遗传定律被来自欧洲几个科学家 deVries, Correns,Tschermark 重新发现,使得生
技术资料暂无技术资料 索取技术资料